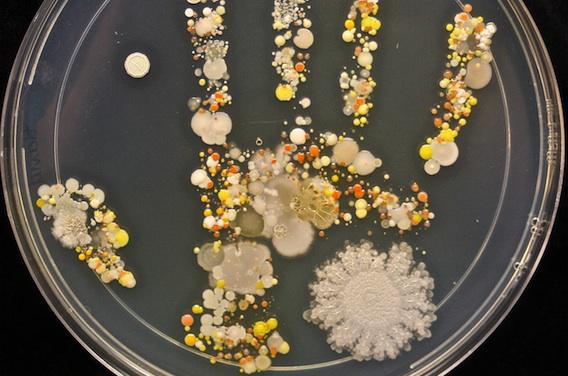

Non, ce n’est pas de l’art, mais le seul moyen qu’une mère a trouvé pour inciter son fils à se laver les mains. Tasha Sturm, biologiste au Cabrillo College (Californie, Etats-Unis), a demandé à son fils de 8 ans de plonger la main dans une boîte de petri après avoir joué dehors. Elle a publié le résultat sur la plateforme imgur. Une jolie photo où apparaît la forme de la main. Mais les petites formes qui ont éclos sont un peu moins ragoûtantes qu’il ne paraît : ce sont des bactéries.
Toutes les bactéries ne sont pas néfastes. Comme le précise Tasha Sturm au Huffington Post américain, « rien dans la boîte n’était terrible. Les bactéries sont partout. Notre système immunitaire se développe à partir d’elles. » Parmi les bactéries récoltées, certaines proviennent de la terre, d’autres du tube digestif.

Seul un organisme soulève le mystère : celui qui s’est développé en dehors de la main du fils de la biologiste.
Selon la chercheuse ce dernier n’a pas vraiment tiré d’enseignement de cette petite expérience. « Il pense que c’est la chose la plus cool de la planète », a-t-elle confié au Huffington Post. Il est à parier donc qu’il ne se lavera pas plus souvent les mains.
Des résultats similaires, bien que moins esthétiques, ont été publiés en 2013 par une équipe de l’université du Surrey (Royaume-Uni). Cette fois, les chercheurs avaient tout simplement posé leur téléphone dans une boîte de petri. A la comparaison des deux clichés, certaines bactéries se ressemblent beaucoup.